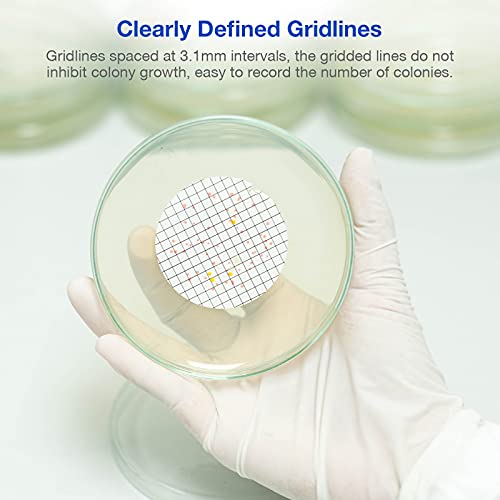
SimPure MCE Gridded Membrane Filter Sterile, 47mm Diameter and 0.45um Pore Size, Individual Pack Membrane Disc Filter, Hydrophilic Filter Paper, Pack of 100
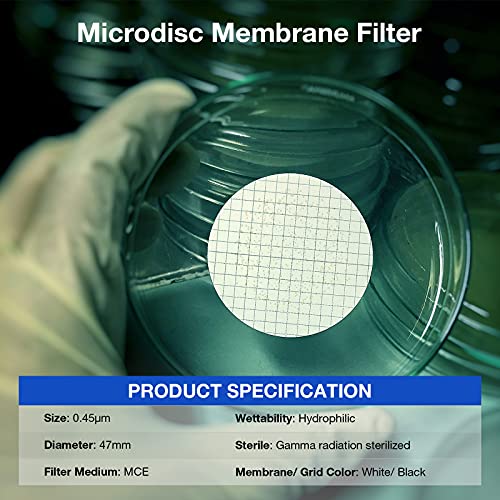
Thumbnail 4
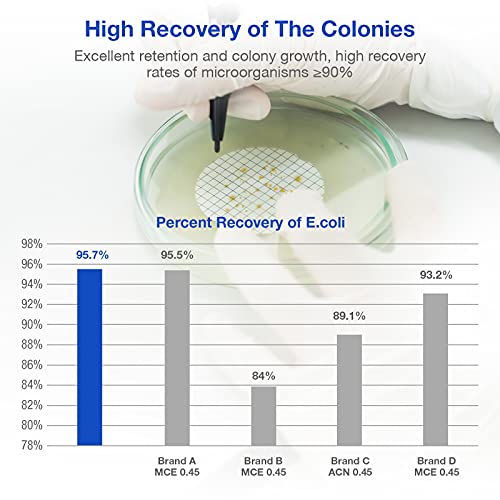
Thumbnail 6
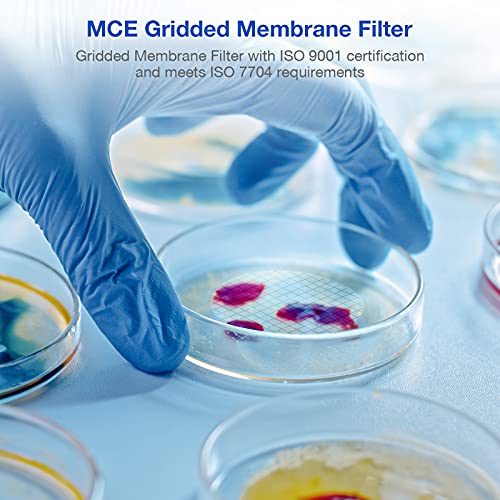
Thumbnail 7

🔬 Elevate your lab game with precision filtration that never quits!
SimPure's sterile MCE gridded membrane filters feature a 47mm diameter and 0.45μm pore size, crafted from biologically inert cellulose acetate and nitrate. Individually packed and irradiation-sterilized, these hydrophilic membranes are designed for superior sterility testing and colony counting, with a unique gridded surface that enhances visibility and reduces eye fatigue during analysis.






| ASIN | B07DK85P6S |
| Best Sellers Rank | #70,744 in Industrial & Scientific ( See Top 100 in Industrial & Scientific ) #3 in Lab Filter Membranes |
| Date First Available | June 7, 2018 |
| Is Discontinued By Manufacturer | No |
| Item Weight | 3.98 ounces |
| Item model number | FMCE047045GWS-100P |
| Manufacturer | Alberts Filter |
| Package Dimensions | 3.5 x 3.25 x 1.75 inches |
G**N
Item as described.
They are as described and same as pictured.
A**D
Useless without suction holder
Wanted to filter undissolved/suspended fluorescein dye from water. Completely failed filtering because it just didn't allow and water flow through it.
J**A
Excellent quality and price
This is a great product, so far works as the top brand membranes. Be aware that this is inexpensive membrane filtration, meaning that most of the protective stuff other brands have is missing here. You need to be more careful in the handling and storage, but the price difference makes it worth the effort.
S**Y
Good filter, good price
Good filters get the job done, packaged nicely and well priced compared to competitors
A**M
Great value...perform as expected.
We purchased these to perform thermotolerant fecal membrane filtration testing. They perform comparably to the ones we used previously from Fisher Scientific that were twice the price of these. These are a great value!
B**Y
Good customer service
Functional. Though Much smaller than expected, not adhesive they did work. And customer service was great
G**A
Don't work in 47mm Funnel, too large.
I can make them work in a 56 mm funnel but to big for universal 47mm, another star off for little information provided on compatibility only really recommend these for biological application.
H**R
Testable
Used for water testing & worked well
ترست بايلوت
منذ شهر
منذ شهر